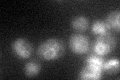
YDL054C
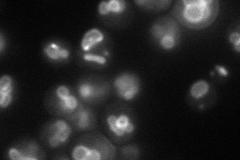
YDL054C
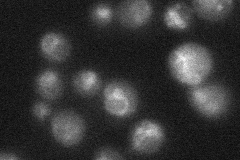
YDL054C
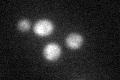
YDL054C
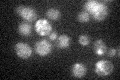
YDL054C

View description
Protein with similarity to mammalian monocarboxylate permeases, which are involved in transport of monocarboxylic acids across the plasma membrane; mutant is not deficient in monocarboxylate transport
Localization:
Intensity:
Fold change:
Significance:
-
C’ GFP library in SD
vacuole membrane22.09 -
N' NOP1pr-GFP in SD
vacuole membrane67.973 -
N' TEF2pr-mCherry in SD

vacuole membrane95.2852 -
N' NATIVEpr-GFP in SD
vacuole membrane30.7204 -
N' TEF2pr-VC and Cyto-VN in SD

below threshold29.9193 -
C’ GFP library in SD+DTT
vacuole membrane19.840.89No -
C’ GFP library in SD+H2O2

vacuole membrane22.791.03No -
C’ GFP library in Starvation Media
vacuole membrane26.241.18No -
C’ GFP library on the background of Pup2-DaMP

vacuole membrane -
C’ GFP library on the background of CCT mutant

vacuole membrane18.86420.853766No
